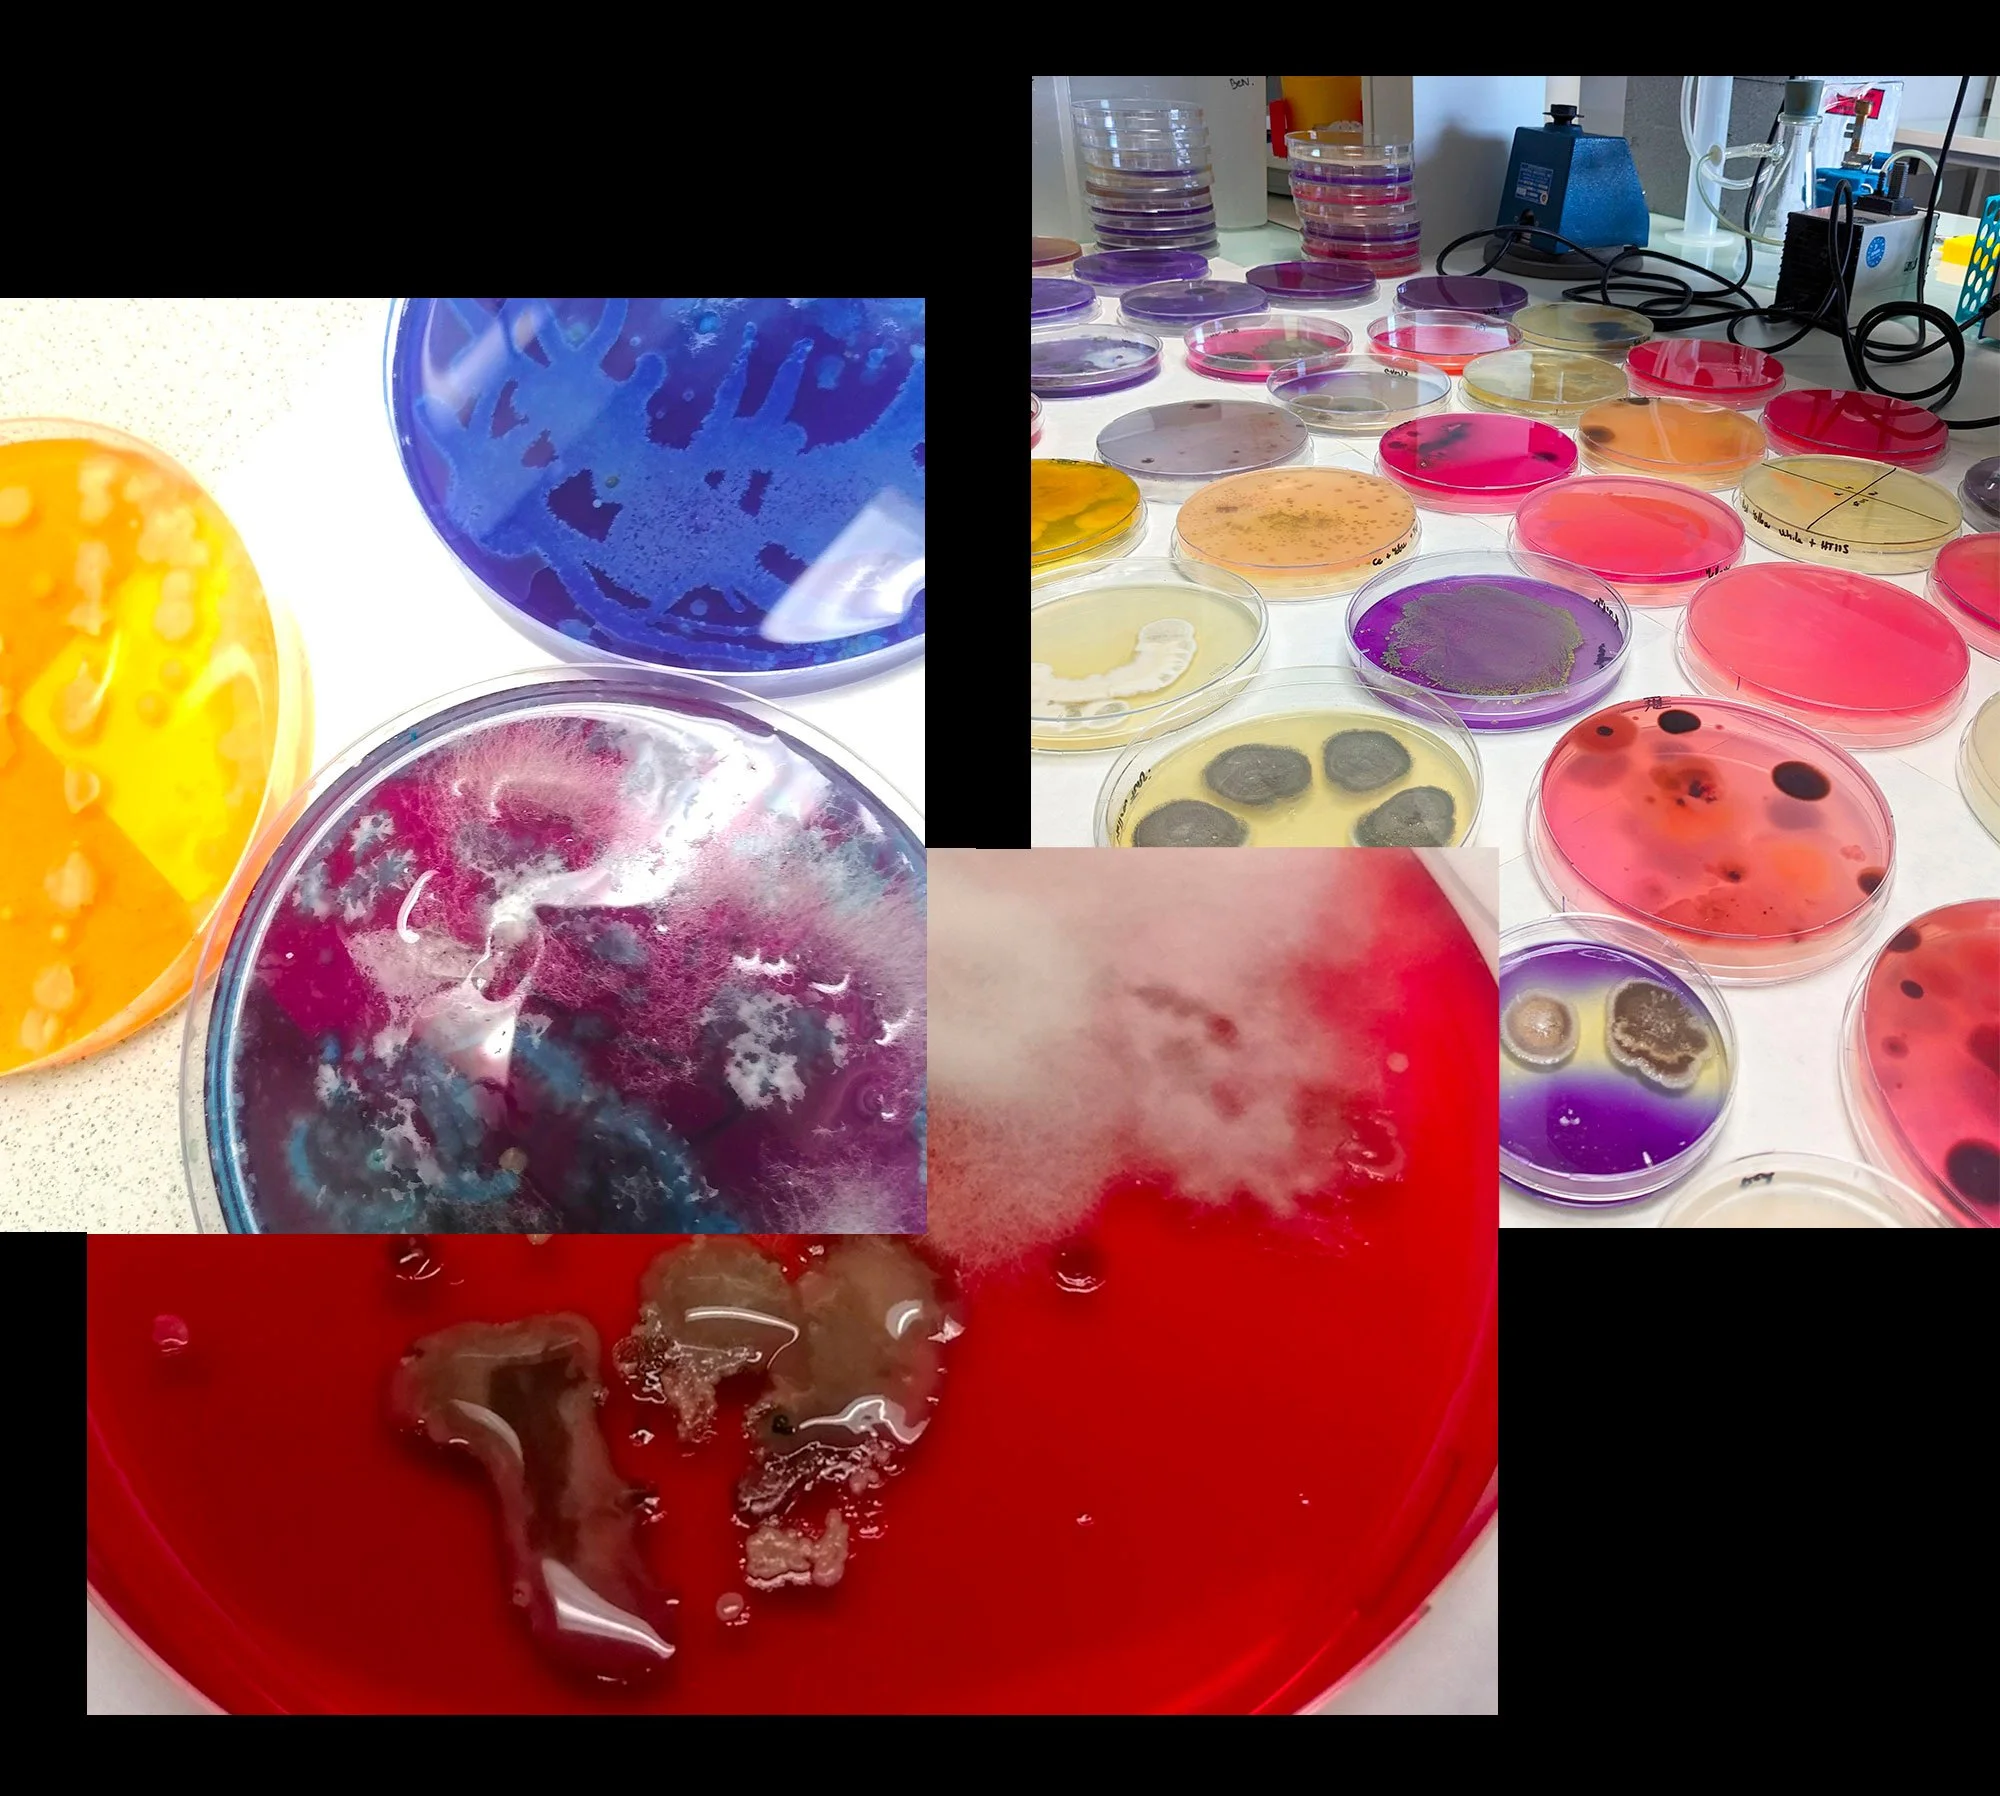

Exposition sur les micro-organismes
Quand l’invisible devient visible
Exposition en collaboration avec le CNRS
Exposition à la Galerie Ephémère / 11 ème édition
L’installation que vous allez découvrir a été conçue en collaboration avec COSA (Connexion Art et Sciences), le CRBM (Centre de recherche en Biologie Cellulaire de Montpellier) et le CNRS (Centre National de la Recherche Scientifique).
Un immense merci à Benjamin Lacroix, membre de COSA et chercheur au CRBM, mon binôme sur ce magnifique projet.


Quand l’invisible devient visible
Nous sommes entouré.es de micro-organismes. Sur la faune, la flore, dans l’eau, l’air, ils sont présents partout partout où nous évoluons.
Graphiste de formation et avec l’envie s’intéresser le public aux sciences , je suis passée par la forme > une surprenante installation, pour interpeler et intéresser le public sur le fond, les sciences.
En collaboration avec le chercheur Benjamin Lacroix, nous avons créé
UNE INSTALLATION COMPOSEE DE MICRO-ORGANISMES


Processus artistique
Des échantillons de feuilles, eaux des salins, brindilles, fleurs ont été récoltées sur le lieu même de la future édition de la Galerie Ephémère.
•
Nous avons ensuite cultivé les micro-organismes (ici principalement diverses bactéries) présents sur ces échantillons, dans des boîtes de pétri. En verre ou en plastique, ces boîtes rondes contiennent un liquide ou gel nutritif appelé gélose (excellente nourriture pour nos micro-organismes, avec une recette bien particulière). Les bactéries en se développant, vont former des visuels attrayants !
•
Des colorants et différents procédés chimiques en réaction au ph des bactéries sont introduits dans les boîtes de pétri.
Un résultat magnifique garanti !
Gélose en préparation
et colorant en action

Exposition sur les micro-organismes



Projet artistique



Micro-organismes






Art et sciences
Vulgarisation scientifique










